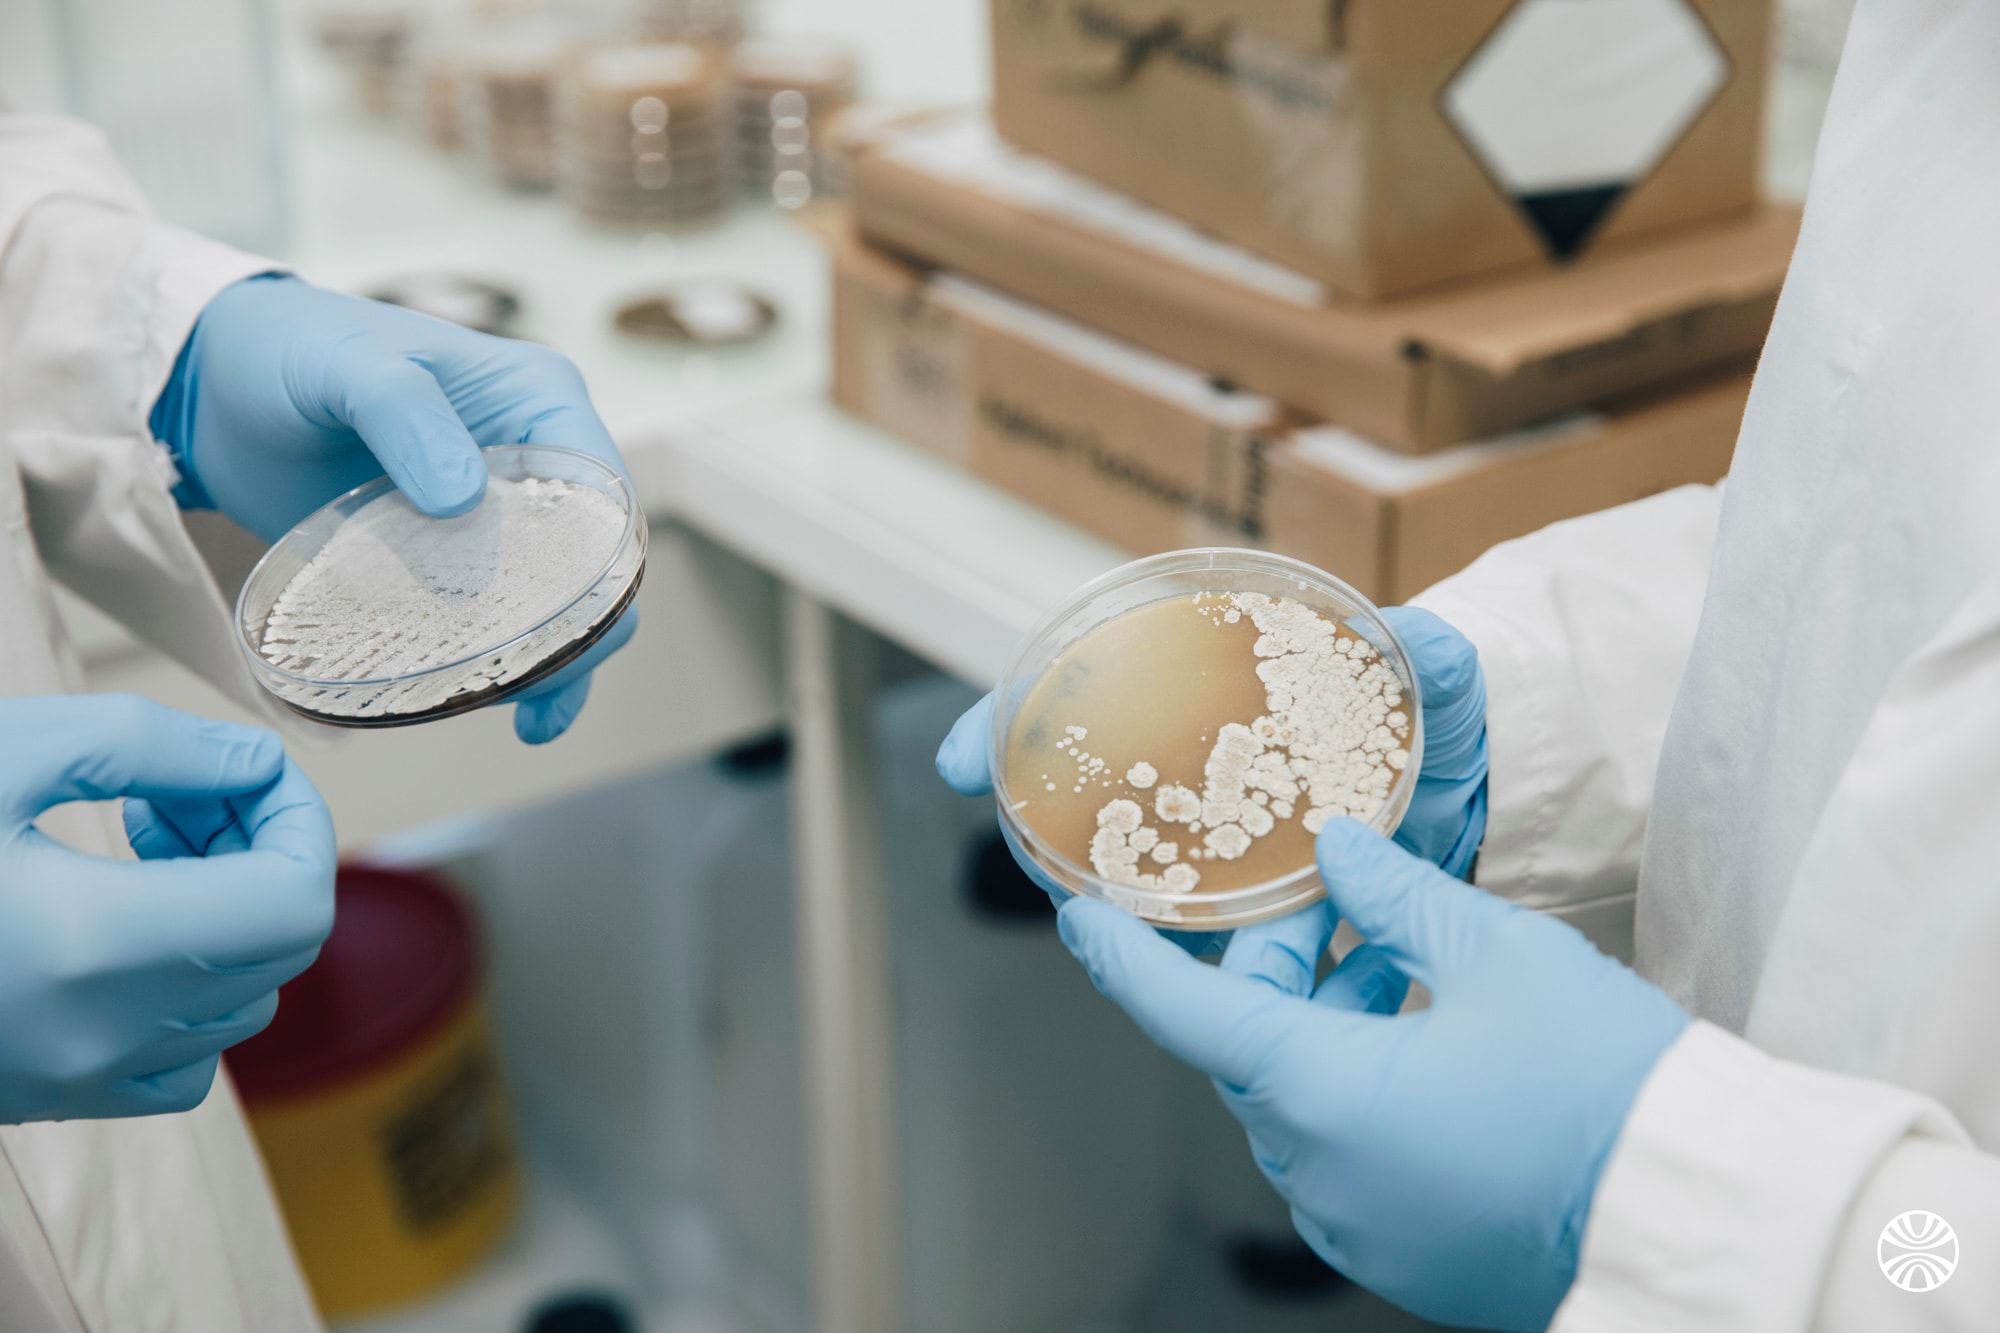
Generare Bioscience Bets Big on AI to Uncover New Drugs

Generare Bioscience Bets Big on AI to Uncover New Drugs
Generare Bioscience lands a €20 million investment to shake up drug discovery with AI. Is this the future of pharmaceuticals or just another biotech bet?
Generare Bioscience, a Parisian upstart, is making waves in the biotech world by using artificial intelligence to unearth molecular data that could pave the way for new drug discoveries. With a fresh infusion of €20 million, roughly $23.3 million, from investors Alven and Daphni, alongside continued support from Galion.exe, Teampact Ventures, and Vives Partners, they've certainly captured attention.
The AI Revolution in Biotech
Founded in 2023, Generare is part of a burgeoning trend where AI's potential in drug development isn't just talked about but actively pursued. But does this mark the dawn of a pharmaceutical revolution or just another hopeful shot in the dark? The biotech sector has seen its fair share of hype, with AI-driven promises often crashing into the harsh shores of reality.
This latest funding round suggests that investors are doubling down on the magic of machine learning to sift through molecular chaos. The goal? To find the needle in a haystack that could lead to groundbreaking treatments. Yet, how many times have we heard that before? The press release said innovation. The 10-K said losses. Spare me the roadmap unless it leads to tangible results.
Investment and Expectation
Let's not kid ourselves. Investors are drawn like moths to a flame by the allure of high-risk, high-reward ventures, and biotech is notorious for its long timelines and uncertain outcomes. Generare's €20 million raise could be seen as a vote of confidence or a calculated gamble, depending on your level of optimism.
In an industry where the stakes are as high as they come, the optics of such investments are important. The question is, will Generare's AI really uncover unknown molecules and advance new drugs, or will it become another cautionary tale in the annals of biotech history? I've seen enough of these promises to know that skepticism is often the safest bet.
The Road Ahead
The challenge for Generare is clear: transform speculative potential into real-world results. The biotech landscape is littered with companies that couldn’t deliver on their lofty promises. To stand out, Generare will need more than just advanced algorithms and fresh funding. They'll need to produce results that turn heads and save lives.
In the end, the potential is there, and the stakes are certainly high enough. Whether Generare can rise to the occasion or not, only time, and data, will tell. But for now, with €20 million in hand, they're certainly in the game. Here's hoping they play it wisely.
Get AI news in your inbox
Daily digest of what matters in AI.
Key Terms Explained
The science of creating machines that can perform tasks requiring human-like intelligence — reasoning, learning, perception, language understanding, and decision-making.
A mechanism that lets neural networks focus on the most relevant parts of their input when producing output.
A branch of AI where systems learn patterns from data instead of following explicitly programmed rules.